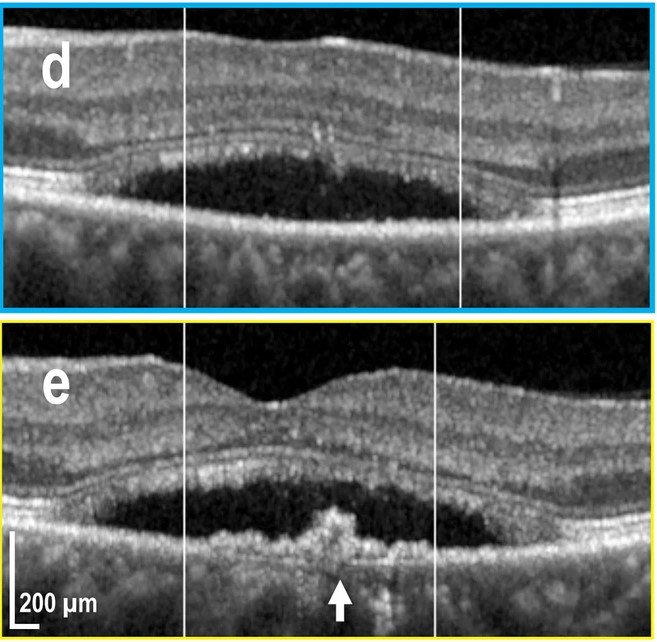

Peer reviewed articles
2025
2024
 |
Nicolet B., Wechsler F., Madrid-Wolff J., Moser C., Jakob W., Inverse Rendering for Tomographic Volumetric Additive Manufacturing, ACM Transactions on Graphics (TOG) 43.6 (2024): 1-17. doi: 10.1145/3687924. |
 |
Unlu B., Alvarez-Castano M. I., Boniface A., Pu Y., Moser C., Single-photon-assisted two-photon polymerization, Additive Manufacturing 94 (2024):104455. doi: 10.1016/j.addma.2024.104455. |
 |
Dinc N. U., Oguz I., Yildirim M., Moser C., Psaltis D., On the implementation of nonlinearities in optical neural networks: opinion, Optical Materials Express 14.10 (2024):2413-2418. doi: 10.1364/OME.536870. |
 |
Sgarminato V., Madrid-Wolff J., Boniface A., Ciardelli G., Tonfa-Turo C., Moser C., 3D in vitro modeling of the exocrine pancreatic unit using tomographic volumetric bioprinting, Biofabrication 16.4 (2024):045034. doi: 10.1088/1758-5090/ad6d8d. |
 |
Yildirim M., Dinc N. U., Oguz I., Psaltis D., Moser C., Nonlinear processing with linear optics, Nature Photonics (2024):1-7. doi: 10.1038/s41566-024-01494-z. |
 |
Govindahari V., Dornier R., Ferdowsi S., Moser C., Mantel I., Behar-Cohen F., Kowalczuk L., High-Resolution Adaptive Optics-Trans-scleral Flood Illumination (AO-TFI) Imaging of Retinal Pigment Epithelium (RPE) in Central Serous Chorioretinopathy (CSCR), Scientific Reports, 14.1 (2024):13689. doi: 10.1038/s41598-024-64524-4. |
 |
Sarkis R., Oguz I., Psaltis D., Paolone M., Moser C.,Lambertini L., Intraday solar irradiance forecasting using public cameras, Solar Energy 275 (2024):112600. doi: 10.1016/j.solener.2024.112600. |
 |
Salaiza D. A. S., Valsangiacomo N., Dinc N. U., Yildirim M., Madrid-Wolff J., Bertsch A., Jiguet S., Dalton P. D., Brugger J., Moser C., Electrowriting of SU-8 Microfibers, Polymers 16.12 (2024):1630. doi: 10.3390/polym16121630. |
 |
Skarsoulis K., Makris K., Moser C., Psaltis D., Ptychographic imaging with a fiber endoscope via wavelength scanning, Optica, Vol. 11, Issue 6, pp. 782-790 (2024). doi: 10.1364/OPTICA.519965. |
 |
Weschsler F., Gigli C., Madrid-Wolff J., Moser C., Wave optical model for tomographic volumetric additive manufacturing, Optics Express Vol. 32, Issue 8, pp. 14705-14712 (2024). doi: 10.1364/OE.521322. |
 |
Barbera L., Madrid-Wolff J., Emma R., Masania K., Boniface A., Loterie D., Delrot P., Moser C., Studart A. R., Multimaterial Volumetric Printing of Silica-Based Glasses, Advanced Materials Technologies (2024). doi: 10.1002/admt.202202117. |
 |
Leong F., Rahmani B., Psaltis D., Moser C., Ghezzi D., An actor-model framework for visual sensory encoding, Nature Communications 15.1 (2024). doi: 10.1038/s41467-024-45105-5. |
 |
Oguz I., Hsieh J., Dinc N. U., Tegin U., Yildirim M., Gigli C., Moser C., Psaltis D., Programming nonlinear propagation for efficient optical learning machines, Advanced Photonics 6.1 (2024). doi: 10.1117/1.AP.6.1.016002. |
 |
Dinc N. U., Moser C., Psaltis D., Volume holograms with linear diffraction efficiency relation by (3 + 1)D printing, Optics Letters 49.2 (2024). doi: 10.1364/OL.508097. |
2023
 |
Somers P., Münchinger A. Maruo S., Moser C., Xu X., Wegener M., The physics of 3D printing with light, Nature Reviews Physics (2023). doi: 10.1038/s42254-023-00671-3. |
 |
Oguz I., Ke J., Weng Q., Yang F., Yildirim M., Dinc N. U., Hsieh J. L., Moser C., Psaltis D., Forward–forward training of an optical neural network, Optics Letters Vol. 48, Issue 20, pp. 5249-5252 (2023). doi: 10.1364/OL.496884. |
 |
Yildirim M., Oguz I., Kaufmann F., Escalé M. R., Grange R., Psaltis D., Moser C., Nonlinear optical feature generator for machine learning, APL Photonics 8, 106104 (2023). doi: 10.1063/5.0158611. |
 |
Madrid-Wolff J., Toombs J., Rizzo R., Bernal P. Porcincula D., Walton R., Wang B., Kotz-Helmer F., Yang Y., Kaplan D., Zhang Y., Zenobi-Wong M., McLeod R., Rapp B., Schwartz J., Shusteff M., Talyor H., Levato R., Moser C., A review of materials used in tomographic volumetric additive manufacturing, MRS Communications (2023). doi: 10.1557/s43579-023-00447-x. |
 |
Boniface A., Maître F., Madrid-Wolff J., Moser C., Volumetric helical additive manufacturing, Light: Advanced Manufacturing 4, 12(2023). doi: 10.37188/lam.2023.012. |
 |
Reizabal A., Kangur T., Saiz P. G., Menke S., Moser C., Brugger J., Dalton P. D., Luposchainsky S., MEWron: An open-source melt electrowriting platform, Additive Manufacturing, 103604 (2023). |
 |
Schoppink J. J., Kriaek J., Moser C., Rivas D. F., Cavitation induced by pulsed and continuous-wave fiber lasers in confinement, Experimental Thermal and Fluid Science, 110926 (2023). |
 |
Caravaca-Aguirre A. M., Poisson F., Bouchet D., Stasio N., Moreau P., Wang I., Zhang E., Beard P., Prada C., Moser C., Demetri P., Ori K., Emmanuel B., Single-pixel photoacoustic microscopy with speckle illumination, Intelligent Computing, (2023). |
 |
Dinc N. U., Saba A., Madrid-Wolff J., Gigli C, Boniface A., Moser C., Psaltis D., From 3D to 2D and back again, Nanophotonics, (2023). |
 |
Zhang Q., Boniface A., Parashar V. K., Gijs M. A., Moser C., Multi-photon polymerization using upconversion nanoparticles for tunable feature-size printing, Nanophotonics, (2023). |
2022
 |
Rahmani B., Psaltis D., Moser C., Variational framework for partially-measured physical system control, NeurIPS 2022. |
 |
Karami P., Rana V. K., Zhang Q., Boniface A., Guo Y., Moser C., Pioletti D., NIR Light-Mediated Photocuring of Adhesive Hydrogels for Noninvasive Tissue Repair via Upconversion Optogenesis, Biomacromolecules, 23, 12, 5007–5017 (2022). |
 |
Kowalczuk L., Dornier R., Kunzi M., Iskandar A., Misutkova Z., Gryczka A., Navarro A., Jeunet F., Mantel I., Behar-Cohen F., Laforest T., Moser C., in vivo Retinal Pigment Epithelium Imaging using Transscleral OPtical Imaging in healthy eyes, Ophthalmology Science, 100234 (2022). |
 |
Konstantinou G., Boniface A., Loterie D., Kakkava E., Psaltis D., Moser C., Improved two-photon polymerization through an optical fiber using coherent beam shaping, Optics and Lasers in Engineering, Vol. 160, 107232 (2022). |
 |
Bonati C., Fay V., Dornier R., Loterie D., Moser C., Lock-in Raman difference spectroscopy, Optics Express Vol. 30, Issue 16, pp. 28601-28613 (2022). |
 |
Gigan S., Katz o., et al., Roadmap on Wavefront Shaping and deep imaging in complex media, Journal of Physics: Photonics, (2022). |
 |
Madrid-Wolff J., Boniface A., Loterie D., Delrot P., Moser C., Controlling light in scattering materials for volumetric additive manufacturing, Advanced Science, 2105144 (2022). |
 |
Bernal P., Bouwmeester M., Madrid-Wolff J., Falandt M., Florczak S., Rodriguez N., Li Y., Größbacher G., Samsom R., Wolferen M., Laan L., Delrot P., Loterie D., Malda J., Moser C., Spee B., Levato R., Volumetric bioprinting of organoids and optically tuned hydrogels to build liver-like metabolic biofactories, Advanced Materials, 2110054 (2022). |
 |
Kollep M., Konstantinou G., Madrid-Wolff J., Boniface A., Hagelüken L., Sasikumar P., Blugan G., Delrot P., Loterie D., Brugger J., Moser C., Tomographic volumetric additive manufacturing of silicon oxycarbide ceramics, Advanced Engineering Materials, 2101345 (2022). |
 |
Soulez F., Rostykus M., Moser C., and Unser M., A constrained method for lensless coherent imaging of thin samples, Applied Optics, Vol. 69, Issue 9 (2022). |
 |
Rahmani B., Oguz I., Tegin U., Hsieh J. L., Psaltis D., Moser C., Learning to image and compute with multimode optical fibers, Nanophotonics, 11(6), 1071-1082., (2022). |
 |
Bonati C., Loterie D., Laforest T., Moser C., Lock-in incoherent differential phase contrast imaging, Photonics Research, Vol. 10, Issue 1 (2022). |
2021
 |
Rahmani B., Psaltis D., Moser C., Variational framework for partially-measured physical system control, NeurIPS 2021. |
 |
Porte X., Dinc U., Moughames J., Panusa G., Juliano C., Kadic M., Moser C., Brunner D., and Psaltis D., Direct (3+1)D laser writing of graded-index optical elements, Optica, 2021. |
 |
Teğin U., Yildirim M., Oğuz I., Moser C., and Psaltis D., Scalable optical learning operator, Nat Comp Sci, 2021. |
 |
Teğin, U., Dinç, N.U., Moser, C. and Psaltis D., Reusability report: Predicting spatiotemporal nonlinear dynamics in multimode fibre optics with a recurrent neural network, Nat Mach Intell, 2021. |
 |
Krizek, J., Lavickova, B., Moser, C., Degradation study on molecules released from laser-based jet injector, International Journal of Pharmaceutics, 120664, 2021. |
 |
Karami, P., Nasrollahzadeh, N., Wyss, C., O’Sullivan, A., Broome, M., Procter, P., Bourban, P.‐E., Moser, C., Pioletti, D. P., An Intrinsically‐Adhesive Family of Injectable and Photo‐Curable Hydrogels with Functional Physicochemical Performance for Regenerative Medicine, Macromol. Rapid Commun. 2021, 2000660. |
 |
Poupart O., Conti R., Schmocker A., Pancaldi L., Moser C., Nuss K. M., Sakar M. S., Dobrocky T., Grützmacher H., Mosimann P. J., and Pioletti D. P., Pulsatile Flow-Induced Fatigue-Resistant Photopolymerizable Hydrogels for the Treatment of Intracranial Aneurysms, Front. Bioeng. Biotechnol., Vol. 8, January 2021. |
2020
 |
Panusa G., Pu Y., Wang J., Moser C., and Psaltis D., Fabrication of Sub-Micron Polymer Waveguides through Two-Photon Polymerization in Polydimethylsiloxane, Polymers, 12, 2485, October 2020. |
 |
Bonati C., Laforest T., Kunzi M., and Moser C., Phase sensitivity in differential phase contrast microscopy: limits and strategies to improve it, Opt. Express 28, 33767-33783, October 2020. |
 |
Teğin U., Rahmani B., Kakkava E., Psaltis D., and Moser C., Single-mode output by controlling the spatiotemporal nonlinearities in mode-locked femtosecond multimode fiber lasers, Adv. Photon. 2(5) 056005, October 2020. |
 |
Krizek J., De Goumoëns F., Delrot P., and Moser C., Needle-free delivery of fluids from compact laser-based jet injector, Lab On a Chip, https://doi.org/10.1039/D0LC00646G, June 2020. |
 |
Teğin U., Rahmani B., Kakkava E., Psaltis D., and Moser C., All-fiber spatiotemporally mode-locked laser with multimode fiber-based filtering, Optics Express, Vol. 28, Issue 16, July 2020. |
 |
Rahmani B., Loterie D., Kakkava E., Borhani N., Teğin U., Psaltis D. & Moser C., Actor neural networks for the robust control of partially measured nonlinear systems showcased for image propagation through diffuse media, Nat Mach Intell, Vol. 2, 403–410 (2020).
Read: https://rdcu.be/b5Dq7 (arXiv download). |
 |
dos Santos F., Laforest T., Künzi M., Kowalczuk L., Behar-Cohen F., and Moser C., Fully automated detection, segmentation, and analysis of in vivo RPE single cells, Eye, June 2020. |
 |
Konstantinou G., Kakkava E., Hagelüken L., Vallachira Warriam Sasikumar P., Wang J., Grazyna Makowska M., Blugan G., Nianias N., Marone F., Van Swygenhoven H., Brugger J., Psaltis D., Moser C., Additive micro-manufacturing of crack-free PDCs by two-photon polymerization of a single, low-shrinkage preceramic resin, Additive Manufacturing, May 2020. |
 |
Poupart O., Schmocker A., Conti R., Moser C., Nuss K. M., Grützmacher H., Mosimann P. J., and Pioletti1 D. P., In vitro Implementation of Photopolymerizable Hydrogels as a Potential Treatment of Intracranial Aneurysms, Front. Bioeng. Biotechnol., April 2020. |
 |
Laforest T., Künzi M., Kowalczuk L., Carpentras D., Behar-Cohen F. and Moser C. , Transscleral optical phase imaging of the human retina, Nature Photonics, March 2020. |
 |
Teğin U., Rahmani B., Kakkava E., Borhani N., Moser C., and Psaltis D., Controlling spatiotemporal nonlinearities in multimode fibers with deep neural networks, APL Photonics, Vol. 5, March 2020. |
 |
Krizek J., Delrot P., and Moser C., Repetitive regime of highly focused liquid microjets for needle-free injection, Scientific Reports, Vol. 10, 2020. |
 |
Loterie D., Delrot P., and Moser C., High-resolution tomographic volumetric additive manufacturing, Nature Communications, Vol. 11, 2020. |
2019
 |
Teğin U., Kakkava E., Rahmani B., Psaltis D., and Moser C., Spatiotemporal self-similar fiber laser, Optica, Vol. 6, 2019. |
 |
Bernal P. N., Delrot P., Loterie D., Li Y., Malda J., Moser C., Levato, R., Volumetric Bioprinting of Complex Living‐Tissue Constructs within Seconds, Advanced Materials, 2019. |
 |
Laforest T., Künzi M., Kowalczuk L., Carpentras D., Behar-Cohen F., Moser C., Transscleral Optical Phase Imaging of the Human Retina – TOPI, pre print, May 15th, 2019. |
 |
Kakkava E., Rahmani B., Borhani N., Teğin U., Loterie D., Konstantinou G., Moser C., and Psaltis D., Imaging through multimode fibers using deep learning: The effects of intensity versus holographic recording of the speckle pattern, Optical Fiber Technology, Vol. 52, 2019. |
 |
Hashemi M., Karnakov P., Hadikhani P., Chinello E., Litvinov S., Moser C., Koumoutsakos P. and Psaltis D., A versatile and membrane-less electrochemical reactor for the electrolysis of water and brine, Energy Environ. Sci., DOI: 10.1039/C9EE00219G, 2019. |
 |
Deng S., Loterie D., Konstantinou G., Psaltis D., and Moser C., Raman imaging through multimode sapphire fiber, Opt. Express, Vol. 27, Issue 2, 2019. |
 |
Kakkava E., Romito M., Conkey D. B., Loterie D., Stankovic K. M., Moser C., and Psaltis D. , Selective femtosecond laser ablation via two-photon fluorescence imaging through a multimode fiber, Biomed. Opt. Express, Vol 10, 423-433, 2019. |
 |
Panusa G., Pu Y., Wang J., Moser C., and Psaltis D., Photoinitiator-free multi-photon fabrication of compact optical waveguides in polydimethylsiloxane, Opt. Mater. Express, Vol. 9, Issue 1, 128-138, 2019. |
2018
 |
Loterie D., Delrot P. and Moser C., Volumetric 3D Printing of Elastomers by Tomographic Back-Projection, pre print, November 8, 2018. |
 |
Karami P., Wyss C.S., Khoushabi A., Schmocker A., Broome M., Moser C., Bourban P., and Pioletti D.P., Composite Double-Network Hydrogels To Improve Adhesion on Biological Surfaces, ACS Appl. Mater. Interfaces, DOI: 10.1021/acsami.8b10735, 2018. |
 |
Rahmani B., Loterie D., Konstantinou G., Psaltis D., Moser C., Multimode optical fiber transmission with a deep learning network, Light: Science & Applications, Vol. 7, Article number 69, 2018. |
 |
Delrot P, Hauser S. P., Krizek J., Moser C., Depth-controlled laser-induced jet injection for direct three-dimensional liquid delivery, Applied Physics A, Vol. 124, Issue 9, 2018. |
 |
Borhani N., Kakkava E., Moser C., Psaltis D., Learning to see through multimode fibers, Optica, Vol. 5, Issue 8, 2018. |
 |
Rostykus M., Rossi M., Moser C., Compact lensless subpixel resolution large field of view microscope, Optics Letters, Vol. 43, Issue 8, 2018. |
 |
Carpentras D., Laforest T., Kunzi M., Moser C., Effect of backscattering in phase contrast imaging of the retina, Optics Express, Vol. 26, Issue 6, 2018. |
 |
Laforest T., Carpentras D., Kunzi M., Kowalczuk L., Behar-Cohen F., Moser C., A new microscopy for imaging retinal cells, arXiv:1712.08472. |
 |
Delrot P., Loterie D., Psaltis D., Moser C., Single-photon three-dimensional microfabrication through a multimode optical fiber, Optics Express, Vol. 26, Issue 2, pp.1766-1778, 2018. |
 |
Rostykus M., Soulez F., Unser M., Moser C., Compact in-line lensfree digital holographic microscope, Methods 136, 2018. |
2017
 |
Chinello E., Modestino M. A., Coulot L., Ackermann M., Gerlich F., Psaltis D., Moser C., A 25.1% efficient stand-alone solar chloralkali generator employing a microtracking solar concentrator, Global Challenges, 1700095, 2017. |
 |
Rostykus M., Moser C., Compact lensless off-axis transmission digital holographic microscope, Optics Express, Vol. 25, Issue 14, pp.16652-16659, 2017. |
 |
Carpentras D., Moser C., See-through ophtalmoscope for retinal imaging, J. Biomed. Opt. 22(5), 056006, 2017. |
 |
Conkey D.B., Kakkava E., Lanvin T., Loterie D., Stasio N., Morales-Delgado E., Moser C., Psaltis D., High power, ultrashort pulse control through a multi-core fiber for ablation, Optics Express, Vol. 25, Issue 10, pp.11491-11502, 2017. |
 |
Loterie D., Psaltis D., Moser C., Bend translation in multimode fiber imaging, Optics Express, Vol. 25, Issue 6, pp.6263-6273, 2017. |
 |
Morales-Delgado E. E., Urio L., Conkey D. B., Stasio N., Psaltis D., Moser C., Three-dimensional microfabrication through a multimode optical fiber, Optics Express, Vol. 25, Issue 6, pp.7031-7045, 2017. |
 |
Rostykus M., Soulez F., Unser M., Moser C., Compact lensless phase imager, Optics Express, Vol. 25, Issue 4, pp.4438-4445, 2017. |
2016
 |
Nardin G., Colomb T., Emery Y., Moser C., Versatile spectral modulation of a broadband source for digital hologrphic microscopy, Optics Express, Vol. 24, Issue 24, pp.27791-27804, 2016. |
 |
Stasio N., Moser C., Psaltis D., Calibration-free imaging through a multicore fiber using speckle scanning microscopy, Optics Letters, Issue 13, pp.3078-3081, 2016. |
 |
Schüttauf J.-W., Modestino A. M., Chinello E., Lambelet D., Delfino A., Dominé D., Faes A., Despeisse M., Bailat J., Psaltis D., Moser C., Baillif C., Solar-to-hydrogen production at 14.2% efficiency with silicon photovoltaics and earth abundant electrocatalysts, Journal of the Electrochemical Society, in Press, 2016. |
 |
Delrot P., Modestino A. M., Gallaire F., Psaltis D., Moser C., Inkjet printing of viscous monodisperse microdroplets by laser-induced flow focusing, Phys. Rev. Applied 6, 024003, 2016. |
 |
Conkey B. D., Stasio N., Morales-Delgado E. E., Romito M., Moser C., Psaltis D., Lensless two-photon imaging through a multicore fiber with coherence-gated digital phase conjugation, J. Biomed. Opt., Vol. 21, Issue 4, 045002, 2016. |
 |
Ives M., Autry T. M., Cundiff S. T., Nardin G., Direct imaging of surface plasmon polariton dispersion in gorld and silver thin films, JOSA B, Vol. 33, Issue 7, pp. C17-C21, 2016. |
 |
Schmocker A., Khoushabi A., Frauchiger A. D., Gantenbein B., Schizas C., Moser C., Bourban P., Pioletti D., A photopolymerized composite hydrogel and surgical implanting tool for a nucleus pulposus replacement, Biomaterials, 88, 110-119, 2016. |
 |
Nardin G., Multidimensional coherent optical spectroscopy of semiconductor nanostructures: a review, Semicond. Sci. and Technol., 31, 023001 (18pp), 2016. |
 |
Psaltis, D; Moser, C, Imaging with multimode fibers, Optics & Photonics, 1047-6938/16/01/24/8, 2016. (or PDF) |
2015
 |
Schmocker A., Khoushabi A., Schizas C., Bourban P., Pioletti D., Moser C., Miniature probe for the delibery and monitoring of a photopolymerizable material, J. Biomed. Opt., 0001, 20(12),127001, 2015. |
 |
Morales-Delgado E. E., Psaltis D., Moser C., Two-photon imaging through a multimode fiber, Optics Express, Vol. 23, Issue 25, pp. 32158-32170, 2015. |
 |
Khoushabi A., Schmocker A., Pioletti D.P., Moser C., Schizas C., Månson J.A., Bourban P.E., Photo-polymerization, swelling and mechanical properties of cellulose fibre reinforced poly(ethylene glycol) hydrogels, Composites Science and Technology, Vol. 119, pp. 93-99, 2015. |
 |
Stasio N., Conkey D. B., Moser C., Psaltis D., Light control in a miltucore fiber using the memory effect, Optics Express, Vol. 23, Issue 23, pp. 30532-30544, 2015. |
 |
Stasio N., Shibukawa A., Papadopoulos I. N., Farahi S., Simandoux O., Huignard J.-P., Bossy E., Moser C., Psaltis D., Towards new applications using capillary waveguides, Biomedical Optics Express, Vol. 6, Issue 12, pp. 4619-4631, 2015. |
 |
Laporte G. P. J., Stasio N., Moser C., Psaltis D., Enhanced resolution in a multimode fiber imaging system, Optics Express, Vol. 23, Issue 21, pp. 27484-27493, 2015. |
 |
Loterie D., Goorden A. S., Psaltis D., Moser C., Confocal microscopy through a multimode fiber using optical correlation, Optics Letters, Vol. 40, Issue 24, pp. 5754-5757, 2015. |
 |
Modestino A. M., Dumortier M., Hashemi H. M. S., Haussener S., Moser C., Psaltis D., Vapor-fed microfluidic hydrogen generator, Lab Chip, 2015. |
 |
Loterie D., Farahi S. Papadopoulos I., Goy A., Psaltis D., Moser C., Digital confocal microscopy through a multimode fiber, Optics Express, Vol. 23, Issue 18, pp. 23845-23858, 2015. Also in SPIE News room. |
 |
Simandoux S., Stasio N., Gateau J., Huignard J.-P., Moser C., Psaltis D., Bossy E., Optical-resolution photoacoustic imaging through thick tissue with a thin capillary as a dual optical-in acoustic-out waveguide, Appl. Phys. Lett. 106, 094102 (2015). |
 |
Morales-Delgado E. E., Farahi S., Papadopoulos N. I., Psaltis D., Moser C., Delivery of focused short pulses through a multimode fiber, Optics Express, Vol. 23, Issue 7, pp. 9109-9120, 2015. |
2014
 |
Zagolla V., Dominé D., Tremblay E., Moser C., Self-tracking solar concentrator with an acceptance angle of 32°, Optics Express, Vol. 22, Issue S7, pp. A1880-A1894, 2014. |
 |
Rodriguez C., Modestino A. M., Psaltis D., Moser C., Design and cost considerations for practical solar-hydrogen generators, Energy Environ. Sci., 2014. |
 |
Monemhaghdoust Z., Montfort F., Emery Y., Depeursinge C., Moser C., Off-axis digital holographic camera for quantitative phase micoscopy, Biomed. Opt. Express, Vol. 5, Issue 6, pp. 1721-1730, 2014. |
 |
Zagolla V., Tremblay E., Moser C., Proof of principle demonstration of a self-tracking concentrator, Optics Express, Vol. 22, Issue S2, pp. A498-A510, 2014. |
 |
Schmocker A., Khoushabi A., Schizas C., Bourban P., Pioletti D., Moser C., Photopolymerizable hydrogels for implants: Monte-Carlo modeling and expermental in vitro validation, J. Biomed. Opt., Vol. 19, Issue. 3, pp. 035004-035011, 2014. |
2013
 |
Farahi S., Ziegler D., Papadopoulos I., Psaltis D., Moser C., Dynamic bending compensation while focusing through a multimode fiber, Optics Express, Vol. 21, Issue 19, pp. 22504-22514, 2013. |
 |
Guillaumee M., Vahdati P., Tremblay E., Mader A., Bernasconi G., Cadarso V., Grossenbacher J., Brugger J., Sprague R., Moser C., Curved holographic combiner for color head worn display, IEEE. Journal of Display Technology, Vol. PP, Issue. 99, 2013. |
| |
Papadopoulos I., Farahi S., Moser C., Psaltis D., Increasing the imaging capabilities of multimode fibers by exploiting the properties of highly scattering media, Opt. Lett, Vol. 38, No. 15, pp. 2776-2778, 2013. |
 |
Papadopoulos I., Simandoux O., Farahi S., Huignard J-P., Bossy E., Psaltis D., Moser C., Optical resolution photoacoustic microscopy by use of a multimode fiber, Appl. Phys. Lett., Vol. 102, Issue 21, pp. 211106, 2013. |
 |
Monemhaghdoust Z., Montfort F., Cuche E., Emery Y., Depeursinge C., Moser C., Full field vertical scanning in short coherence digital holographic microscope, Optics Express, Vol. 21, Issue 10, pp. 12643-12650, 2013. |
 |
Papadopoulos I., Farahi S., Moser C., Psaltis D., High-resolution, lensless endoscope based on digital scanning through a multimode optical fiber, Biomed. Opt. Express, Vol. 4, Issue 2, pp. 260-270, 2013. |
2012
 |
Tremblay E., Loterie D., Moser C., Thermal phase change actuator for self-tracking solar concentration, Optics Express, Vol. 20, Issue S6, pp. A964-A976, 2012. |
 |
Zagolla V., Tremblay E., Moser C., Light induced fluidic waveguide coupling, Optics Express, Vol. 20, Issue S6, pp. A924-A931, 2012. |
 |
Papadopoulos I., Farahi, S., Moser C., Psaltis D., Focusing and scanning light through a multimode optical fiber using digital phase conjugation, Optics Express, Vol. 20, Issue 10, pp. 10583-10590, 2012. |
2011
 |
Monemhaghdoust Z., Montfort F., Emery Y., Depeursinge C., Moser C., Dual wavelength full field imaging in low coherence digital holographic microscopy, Optics Express, Vol. 19, Issue 24, pp. 24005-24022, 2011. |
 |
Havermeyer F., Ho L., Moser C., Compact single mode tunable laser using a digital micromirror device, Optics Express Vol. 19, Issue 15, pp. 14642-14652, 2011. |
2010 and before
 |
Moser C., Havermeyer F., Ultra-narrowband tunable laserline notch filter, Appl. Phys. B, Vol. 95 Issue 3, pp. 597-601, 2009. |
 |
Hieta T., Vainio M., Moser C., Ikonen E., External-cavity lasers based on a volume holographic grating at normal incidence for spectroscopy in the visible range, Opt. Comm., Vol. 282, Issue 15, pp. 3119-3123, 2009. |
 |
Moser C., Ho L., Havermeyer F., Self-aligned Non-dispersive External Cavity Tunable Laser, Optics Express, Vol. 16, Issue 21, pp. 16691-16696, 2008. |
 |
Moser C., Maye E., Havermeyer F., Ho L., Fabrication and applications of volume holographic optical filters in glass , J. Phys. D: Appl. Phys., Vol. 41, No. 22, pp. 224003, 2008. |
| |
Steckman GJ., Moser C., et al., Volume holographic grating wavelength stabilized laser diodes, IEEE J. Of Selected Topics in Quantum Electronics, Vol. 13, Issue 3, pp. 672-678, 2007. |
Hsieh, HT; Liu, WH; Havermeyer, F, Moser C., Psaltis D., Beam-width-dependent filtering properties of strong volume holographic gratings ,App. Opt. 45 (16), pp. 3774-3780, 2006.
Blais-Ouellette S, Artigau, T, Havermeyer F, Moser C., Multi-notch holographic filters for atmospheric lines suppressionOPTICAL FABRICATION, METROLOGY, AND MATERIAL ADVANCEMENTS FOR TELESCOPES 5494, pp. 554-561, 2004.
Havermeyer, F; Liu, WH; Moser, C, et al. Volume holographic grating-based continuously tunable optical filter , Opt. Eng. 43 (9), pp. 2017-2021, 2004.
Moser, C; Liu, WH; Fainman, Y, et al. Folded shift multiplexing, Opt.Lett. 28 (11), pp. 899-901, 2003.
Moser C., Psaltis D. Holographic Memory With Localized Recording, App. Opt, 40 (23), pp. 3909-3914, 2001.
Turukhin AV, Gorokhovsky AA, Moser C, Psaltis D., Spectral hole burning in naphthalocyanines derivatives in the region 800 nm for holographic storage applications,J. Lumin. 86: (3-4), pp. 399-405, 2000.
Moser C, Kampmeier J, McDonnell P, et al. Feasibility of intraoperative corneal topography monitoring during photorefractive keratectomy, J. Refract. Surg. 16: (2), pp. 148-154, 2000.
Moser C., Maravic I. , Schupp B., Adibi A, Psaltis D, Diffraction efficiency of localized holograms in doubly doped LiNbO3 crystals, Opt. Lett. 25: (17), pp.1243-1245, 2000.
Books
Buse K, Havermeyer F, Liu W., Moser C. and Psaltis D. Holographic Filters , Book Chapter Photorefractive Materials and their Applications, Springer Series in Optical Sciences, 2005.
Articles Magazines
Moser, C; Steckman, G, Filters to Bragg about , Photonics Spectra, 39 (6), 82-85, 2005.

Psaltis, D; Moser, C, Imaging with multimode fibers, Optics & Photonics, 1047-6938/16/01/24/8, 2016. (or PDF)
Proceedings articles
2014
- Monemhaghdoust Z., Montfort F., Emery Y., Depeursinge C., Moser C., Portable advanced off-axis camera for quantitative phase microscopy, Proc. SPIE 8949, Three-Dimensional and Multidimensional Microscopy, San Francisco, CA, February 1-6, 2014.
- Zagolla V., Tremblay E., Moser C., Self-tracking phase change concentrator device demonstrator, Proc. SPIE 9175, High and Low Concentrator Systems for Solar Energy Applications IX, San Francisco, CA, February 1-6, 2014.
2013
- Monemhaghdoust Z., Montfort F., Emery Y., Depeursinge C., Moser C., Surface topography and vertical scanning in two color low coherence digital holographic microscope, Digital Holography and Three-Dimensional Imaging, Kohala Coast, Hawaii, April 21-25, 2013.
- Zagolla V., Tremblay E., Moser C., Efficiency of a micro-bubble reflector based, self-adaptive waveguide solar concentrator, Proc. SPIE 8620, Physics, Simulation, and Photonic Engineering of Photovoltaic Devices II, San Francisco, CA, February 2-7, 2013.
- Tremblay E., Zagolla V., Loterie D., Moser C., Self-tracking planar concentrator using a solar actuated phase-change mechanism, Proc. SPIE 8620, Physics, Simulation, and Photonic Engineering of Photovoltaic Devices II, San Francisco, CA, February 2-7, 2013.
- Schmocker A., Khoushabi A., Farahi S., Pioletti D., Bourban P-E., Manson J-A., Moser C., Multi-scale modeling of photopolymerization for medical hydrogel-implant design, Proc. SPIE 8592, Biomedical Applications of Light Scattering VII, San Francisco, CA, February 2-7, 2013.
- Monemhaghdoust Z., Montfort F., Emery Y., Depeursinge C., Moser C., Quantitative phase noise in a two-color low coherence digital holographic microscope, Proc. SPIE 8644, Practical Holography XXVII: Materials and Applications, San Francisco, CA, February 2-7, 2013.
- Papadopoulos I., Farahi S., Moser C., Psaltis D., Focused light delivery and all optical scanning from a multimode optical fiber using digital phase conjugation, Proc. SPIE 8576,Optical Fibers and Sensors for Medical Diagnostics and Treatment Applications XIII, San Francisco, February 2-7, 2013.
- Guillaumée M., Vahdati S P., Tremblay E., Mader A., Cadarso V J., Grossenbacher J., Brugger J., Sprague R., Moser C., Curved transflective holographic screens for head-mounted display, Proc. SPIE 8643, Advances in Display Technologies III, San Francisco, February 2-7, 2013.
2012
- Zagolla V., Tremblay E., Moser C., Opto-Fluidic Waveguide Coupling, Optics for Solar Energy, Liminescent/Planar Concentrators (ST2A), Eindhoven, Netherlands, November 11-14, 2012.
- Tremblay E., Loterie D., Moser C., Phase-change actuator for self-tracking planar solar concentrator, Optics for Solar Energy, Concentrator Optics and Spectrum Splitting (SM2A), Eindhoven, Netherlands, November 11-14, 2012.
- Zagolla V., Moser C., Trackfree planar solar concentrator system, Physics, Simulation, and Photonic Engineering of Photovoltaic Devices, volume 8256, San Francisco, CA, January 21-26, 2012.
- Monemhaghdoust Z., Montfort F., Emery Y., Depeursinge C., Moser C., Single shot dual wavelength full field imaging in low coherence digital holographic microscopy, Practical Holography XXVI: Materials and Applications, volume 8281, San Francisco, CA, January 21-26, 2012.
- Havermeyer F., Moser C., Logan R-T., Ho L., Demers J-R, Miniature self-aligned external cavity tunable single frequency laser for THz imaging, Terahertz Technology and Applications V, volume 8261, San Francisco, CA, January 23-26, 2012.
2010 and before
- Moser, C; Havermeyer, F, Compact Low Frequency Raman Spectroscopy System, 22nd International Conference on Raman Spectroscopy, Date: AUG 08-13, 2010 Boston MA , XXII INTERNATIONAL CONFERENCE ON RAMAN SPECTROSCOPY Volume: 1267 Pages: 794-795 , 2010.
- Moser, C; Havermeyer, F, Distortion free pulse stretching and compression by chirped volume holographic gratings, Conference on High Energy/Average Power Lasers and Intense Beam Applications IV, Date: JAN 25-26, 2010 San Francisco CA , HIGH ENERGY/AVERAGE POWER LASERS AND INTENSE BEAM APPLICATIONS IV Volume: 7581 Article Number: 75810E , 2010.
- Moser, C; Ho, L; Havermeyer, F, Compact, fast multi-wavelength switchable single frequency laser
Conference Information: Conference on Laser Resonators and Beam Control XII, Date: JAN 24-27, 2010 San Francisco CA , LASER RESONATORS AND BEAM CONTROL XII Volume: 7579 Article Number: 757905, 2010.
- Moser, C; Havermeyer, F, Compact Raman spectrometer system for low frequency spectroscopy, Conference on Optical Components and Materials VII, Date: JAN 26-28, 2010 San Francisco CA , OPTICAL COMPONENTS AND MATERIALS VII Volume: 7598 Article Number: 75980S , 2010.
- Moser, C; Ho, L; Havermeyer, F , A novel tunable diode laser using volume holographic gratings Conference on Solid State Lasers XVIII – Technology and Devices, Date: JAN 25-29, 2009 San Jose CA SOLID STATE LASERS XVIII: TECHNOLOGY AND DEVICES Volume: 7193 Article Number: 71930V, 2009.
- Moser, C; Havermeyer, F , Compact self-aligned external cavity lasers using volume gratings, Conference on Laser Resonators and Beam Control XI, Date: JAN 26-27, 2009 San Jose CA, LASER RESONATORS AND BEAM CONTROL XI Volume: 7194 Article Number: 71940F , 2009.
Bulletins
Moser C., Papadopoulos I., Farahi S., Psaltis D., Endomicroscopy with multi-mode fibers, SSOM bulletin, 2012.